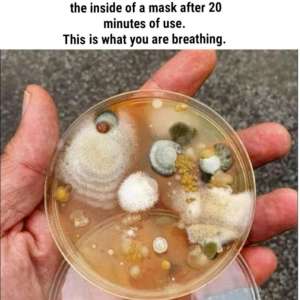
Image

If they try to bring back masks and lockdowns in florida, I am NOT complying! And this time, I will say things to people if they give me any direct shit
when my family tells me it is dangerous, I will force them to explain and justify themselves and explain myocarditis and children to me
and I will never agree to it
when my family tells me it is dangerous, I will force them to explain and justify themselves and explain myocarditis and children to me
and I will never agree to it
10:59 AM - Dec 04, 2023
Only people mentioned by IMPatriotRU in this post can reply
SusieQ Freedom
@Luckysusi
05 December, 06:36
In response CM_ Patriot to her Publication
Screw them! Flat out not doing it! Also not falling for their scary WHITE LUNG disease either. Basturds!! 👿
Notice: Undefined index: tg1tga_access in /home/admin/www/anonup.com/themes/default/apps/timeline/post.phtml on line 396
CM_ Patriot
@IMPatriotRU
05 December, 09:45
In response SusieQ Freedom to her Publication
💯
Notice: Undefined index: tg1tga_access in /home/admin/www/anonup.com/themes/default/apps/timeline/post.phtml on line 396
Crumb Catcher
@CrumbCatcher
04 December, 12:53
In response CM_ Patriot to her Publication
I never wore one.
Notice: Undefined index: tg1tga_access in /home/admin/www/anonup.com/themes/default/apps/timeline/post.phtml on line 396
CM_ Patriot
@IMPatriotRU
04 December, 12:55
In response Crumb Catcher to her Publication
I was not allowed to go to some places without one, so I made it quick, but I avoided going anywhere they wanted one.
If they try it again, I will be a rock and say no, shove it!
If they try it again, I will be a rock and say no, shove it!
Notice: Undefined index: tg1tga_access in /home/admin/www/anonup.com/themes/default/apps/timeline/post.phtml on line 396
Here KittyKitty
@HereKittyKitty
04 December, 12:19
In response CM_ Patriot to her Publication
Here's a bit of info from several different angles, if you need for the mask nazis.
The one about the nano worms is very real -- have talked to several people (in person) who developed "rosacea" after wearing the blue masks; interestingly enough, the "rosacea" goes away in a couple of days by dabbing ivermectin paste on the lesions.
The one about the nano worms is very real -- have talked to several people (in person) who developed "rosacea" after wearing the blue masks; interestingly enough, the "rosacea" goes away in a couple of days by dabbing ivermectin paste on the lesions.
Notice: Undefined index: tg1tga_access in /home/admin/www/anonup.com/themes/default/apps/timeline/post.phtml on line 396
CM_ Patriot
@IMPatriotRU
04 December, 12:23
In response Here KittyKitty to her Publication
Notice: Undefined index: tg1tga_access in /home/admin/www/anonup.com/themes/default/apps/timeline/post.phtml on line 396
Mare Qay - WWG1WGA!
@Patriot63
04 December, 11:56
In response CM_ Patriot to her Publication
Notice: Undefined index: tg1tga_access in /home/admin/www/anonup.com/themes/default/apps/timeline/post.phtml on line 396
04 December, 11:24
(E)
In response CM_ Patriot to her Publication
I did not comply the first time. My husband, retired navy, was embarrassed. He is awake now and says he will NOT comply either. Making progress!!!
Notice: Undefined index: tg1tga_access in /home/admin/www/anonup.com/themes/default/apps/timeline/post.phtml on line 396
CM_ Patriot
@IMPatriotRU
04 December, 11:35
In response Forever Patriot to his Publication
💖
I don't want to see older people and children with a mask on
I don't want to see older people and children with a mask on
Notice: Undefined index: tg1tga_access in /home/admin/www/anonup.com/themes/default/apps/timeline/post.phtml on line 396